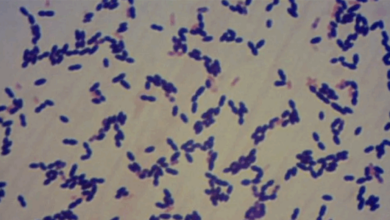

عند تناول 15 حبة من الفستق… هذا ما يحصل لجسمك

وتشير الخبيرة في حديث لوكالة نوفوستي الروسية للأنباء، إلى أن الفستق يحتوي على سعرات حرارية عالية، ولكن مع ذلك يجب ضمه إلى النظام الغذائي لأنه يساعد على تسريع عملية التمثيل الغذائي، ويحسن عمل القلب والأوعية الدموية.
وتقول، “أهم العناصر الرئيسية في الفستق هو فيتامين B7 (البيوتين) الذي يساعد على امتصاص البروتين وحرق الدهون. أي أنه مفتاح عملية التمثيل الغذائي. فعند نقص البروتين في الجسم يسبب مشكلات في الجلد والشعر وتظهر علامات الاكتئاب المزاجي، ويمكن أن يسبب ارتفاع مستوى الكوليسترول “الضار” في الدم”.
وتضيف، “كما يحتوي الفستق على نسبة عالية من البوتاسيوم والمغنيسيوم، ما يساعد على تعزيز الأوعية الدموية وتحسين عمل القلب.
وتقول، “لكي نحصل على أكبر فائدة من الفستق، يجب تناول 15 حبة منه يوميا، والأطفال 7 حبات فقط”.
وتحذر الخبيرة، من أن الفستق مثله مثل بقية المكسرات يمكن أن يسبب الحساسية. وأن 100 غرام من الفستق تحتوي على 550-560 سعرة حرارية.
( نوفوستي)
مصدر الخبر
للمزيد Facebook